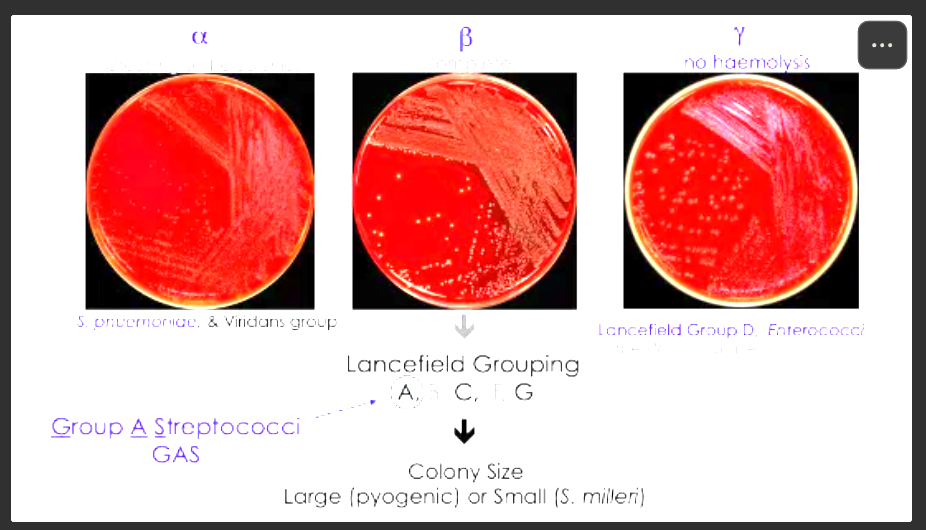

What is colonisation ?
Establishment of microorganisms on or within a host without causing disease, which can lead to infections under certain conditions.
What does virulence mean ?
The capacity of a microbe to cause damage to its host
What is a comensal organism ?
Rrganism that is part of the normal flora
-Often a mutualistic relationship
-Endogenous
What is an oppurtunistic pathogen ?
An organism that causes infection when opportunity/change in natural immunity arises
What are coagulase tests used to differentitate between ?
Between Staph. aureus and coagulase negative Staph. (including Staph epidermis)
What is haemolysis used to differentiate between ?
Used to differentiate between Streptococci
What does sepsis cause ?
Patients with Gram-negative sepsis get very unwell very quickly due to endotoxin released when Gram-negative bacteria die
-Small blood vessels become ‘leaky’ and loose fluid into tissues; decreased blood volume so heart has to work harder
-Poor tissue perfusion means blood supply to less essential organs is shut down
-Blood clotting system activated; uses all clotting factors, increasing risk of haemorrhage
How are fevers caused ?
- Antigen/LPS interacts with macrophages
- Macrophages release cytokines into bloodstream
- Cytokines travel to anterior hypothalamus
- Prostaglandin E released - increases body’s thermal set point
- Body perceives it as cold - starts to ‘shiver’
- FEVER
LPS = Lipopolysaccharides
Give examples of gram negative cocci
Neisseria meningitidis: most common cause of bacterial meningitis
Neisseria gonorrhoeae: gonorrhea
Gram-negative aerobic cocci
Cocci = balls
Give examples of Gram-negative bacilli associated with GI tract
Gut commensal coliforms
-Many are part of normal bowl flora
-Any coliform that gets into a normally sterile environment can cause infection e.g. UTI
-Gentamicin is the first line antibiotic for the treatment of infections caused by coliforms (when urosepsis; first line is generally nitro or trim)
Facultative anaerobies
Give examples of gram-positive pathogens
All streptococci (facultative anaerobic)
Staphylococcus epidermis (facultative anaerobes)
Staphylococcus aureus (facultative anaerobes)
Enterococcus (faculttaive anaerobes)
Clostridium spp. (anaerobic)
spp. = species (several/various/many)
Give examples of streptococci
Group A strep (GAS): numerous associated diseases e.g. Scarlet fever, impetigo, β-haemolytic (same thing as pyogenes)
Streptococcus pneumoniae: pneumonia, ⍺-haemolytic
Only streptococcus identified by haemolysis
Are all gram-positive, facultative-anaerobes
What is Staphylococcus epidermis?
Nosocomial - associated with foreign devices e.g. catheters
Coagulase negative (coagulase produced to form clots around bacteria from fibrinogen into fibrin, helps avoid immune and protection from phagocytosis)
Gram pos, facultative anarobe
Nosocomial: originating in hospital
What is Staphylococcus aureus
-Nosocomial and community
-Most common cause of skin, soft tissue and wound infection
-Sepsis
-Coagulase positive (appears golden); fibrinogen found in loads of places not just in blood e.g. tissue fluid, inflammation exudate, absesses,
-Clump forming - looks like grapes
Gram pos
What is Enterococcus
-Enteric infections
-Part of normal bowel flora, can cause problems if they get into a normally sterile area
-𝛾-haemolytic (none)
Gram pos
What are Clostridium spp. ?
-Part of normal bowel flora
-Produce endotoxins that can cause severe tissue damage
-Clostridium difficile: causes antibiotic-associated diarrhoea, especially in the elderly; Proliferates in the absence of normal flora
Gram pos anaerobic
Give examples of gram negative and positive bacteria



